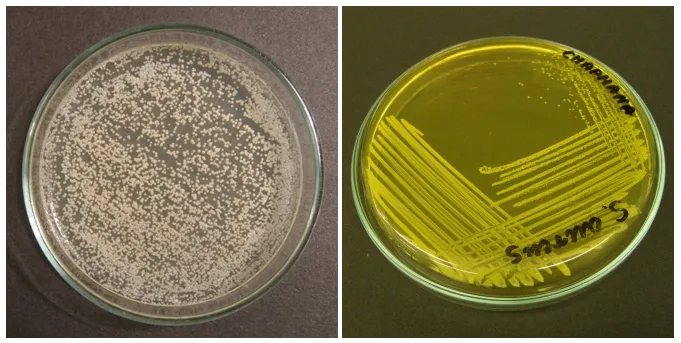

Enterococcus faecalis w nasieniu: co to za bakteria i jak ją leczyć?
Enterococcus faecalis to groźna bakteria, która może występować w nasieniu mężczyzn. Ta infekcja może powodować wiele nieprzyjemnych objawów i komplikacji, dlatego warto wiedzieć, jak ją właściwie zdiagnozować i leczyć. W tym artykule postaramy się wyjaśnić, czym jest Enterococcus faecalis, jakie ma objawy, co może być jego przyczyną oraz jak można pozbyć się tej bakterii i zapobiegać kolejnym infekcjom. Kluczowe wnioski:- Enterococcus faecalis to groźna bakteria, która może zainfekować nasienie mężczyzn i prowadzić do poważnych problemów zdrowotnych.
- Objawy infekcji to m.in. ból, swędzenie, zmiany w wyglądzie i konsystencji nasienia.
- Przyczyną występowania Enterococcus faecalis w nasieniu mogą być słabe nawyki higieniczne, choroby przenoszone drogą płciową lub inne czynniki.
- Diagnostyka polega na badaniach mikrobiologicznych nasienia, a leczenie obejmuje antybiotykoterapię pod nadzorem lekarza.
- Ważne jest również wdrożenie działań profilaktycznych, takich jak poprawa higieny intymnej i regularne badania kontrolne.
Czym jest Enterococcus faecalis w nasieniu?
Enterococcus faecalis to gatunek bakterii, który może występować w nasieniu mężczyzn. Jest to dość powszechna infekcja, która może wywoływać szereg nieprzyjemnych objawów i konsekwencji zdrowotnych. Bakteria enterococcus faecalis jest znana ze swojej odporności na wiele antybiotyków, co może utrudniać jej leczenie.
Obecność bakterii enterococcus faecalis w nasieniu może mieć negatywny wpływ na płodność mężczyzny oraz zwiększać ryzyko przeniesienia infekcji na partnerkę podczas stosunku. Dlatego wczesne rozpoznanie i właściwe leczenie to kluczowe elementy w walce z tym problemem.
Aby zrozumieć, czym jest enterococcus faecalis w nasieniu, warto poznać jego charakterystykę, objawy i potencjalne przyczyny występowania. Tylko kompleksowe podejście pozwoli skutecznie pozbyć się tej infekcji i uniknąć jej nawrótów w przyszłości.
W dalszej części artykułu omówimy szczegółowo wszystkie kluczowe aspekty związane z bakterią enterococcus faecalis w nasieniu i podpowiemy, jak ją skutecznie wyleczyć.
Objawy infekcji Enterococcus faecalis w nasieniu
Obecność bakterii enterococcus faecalis w nasieniu może objawiać się na różne sposoby. Najczęstsze symptomy to ból, pieczenie lub świąd w okolicy narządów płciowych. Może również wystąpić zmiana w wyglądzie lub konsystencji nasienia, które może być mętne, grudkowate lub nieprzejrzyste.
W niektórych przypadkach infekcja bakterią enterococcus faecalis może prowadzić do zapalenia najądrzy lub jąder, co wiąże się z dodatkowym dyskomfortem i bólem. Poważne powikłania, takie jak niepłodność, są rzadsze, ale mogą wystąpić, jeśli infekcja nie zostanie skutecznie wyleczona.Warto pamiętać, że nie każdy mężczyzna z bakterią enterococcus faecalis w nasieniu będzie odczuwał wyraźne objawy. Niektórzy mogą być nosicielami tej bakterii, nie wykazując żadnych dolegliwości. Dlatego regularne badania kontrolne są tak ważne, by wykryć problem na wczesnym etapie.
Jeśli zauważysz u siebie niepokojące oznaki, takie jak zmiany w nasieniu lub dolegliwości w okolicy narządów płciowych, nie zwlekaj i skonsultuj się z lekarzem. Szybka diagnoza i leczenie to klucz do pozbycia się bakterii enterococcus faecalis z Twojego organizmu.
Przyczyny występowania Enterococcus faecalis w nasieniu
Bakteria enterococcus faecalis może pojawić się w nasieniu z kilku powodów. Jedną z głównych przyczyn jest słaba higiena intymna lub zaniedbanie tej sfery. Nieodpowiednia pielęgnacja narządów płciowych sprzyja namnażaniu się różnych drobnoustrojów, w tym właśnie enterococcus faecalis.
Inną możliwą przyczyną jest przebyta lub istniejąca infekcja przenoszona drogą płciową. Niektóre choroby, takie jak rzeżączka czy chlamydioza, mogą osłabiać naturalne mechanizmy obronne organizmu i ułatwiać kolonizację przez bakterię enterococcus faecalis.
Istotną rolę mogą także odgrywać ogólne problemy ze zdrowiem, np. cukrzyca lub obniżona odporność. W takich przypadkach ryzyko infekcji bakterią enterococcus faecalis znacznie rośnie.
Warto też zauważyć, że niektórzy mężczyźni po prostu mogą być nosicielami bakterii enterococcus faecalis w nasieniu, nawet bez wyraźnych objawów chorobowych. Ta bezobjawowa kolonizacja również może prowadzić do powikłań, dlatego należy ją na bieżąco monitorować.
Badania i diagnozowanie Enterococcus faecalis w nasieniu
Jeśli podejrzewasz, że masz problem z bakterią enterococcus faecalis w nasieniu, kluczowe jest przeprowadzenie odpowiednich badań. Podstawową metodą diagnostyczną jest posiew nasienia, który pozwoli zidentyfikować obecność i liczbę tych bakterii.
Dodatkowo lekarz może zalecić również badanie ogólne nasienia, by ocenić jego jakość i wykryć ewentualne inne nieprawidłowości. W niektórych przypadkach konieczne będą też testy na obecność innych, możliwych infekcji przenoszonych drogą płciową.
Warto pamiętać, że samo wykrycie bakterii enterococcus faecalis w nasieniu nie zawsze jest równoznaczne z koniecznością leczenia. Istotna jest również ocena stanu klinicznego pacjenta i nasilenia objawów. Dlatego ostateczna decyzja o terapii zawsze należy do lekarza.
Jeśli stwierdzisz obecność bakterii enterococcus faecalis w nasieniu, nie zwlekaj z wizytą u specjalisty. Szybkie podjęcie odpowiednich działań znacznie ułatwi wyleczenie infekcji i zapobiegnie poważniejszym powikłaniom.
Leczenie Enterococcus faecalis w nasieniu
Podstawową metodą leczenia bakterii enterococcus faecalis w nasieniu jest antybiotykoterapia. Lekarz, na podstawie wyników posiewu i oceny stanu pacjenta, dobierze odpowiedni antybiotyk, który skutecznie zwalczy tę infekcję.
Warto pamiętać, że bakteria enterococcus faecalis jest dość odporna na wiele leków przeciwbakteryjnych, więc czasem konieczne będzie zastosowanie kilku różnych antybiotyków lub dłuższe leczenie. Lekarz będzie ściśle monitorował efekty terapii.
Oprócz antybiotyków ważne jest również wdrożenie odpowiednich działań higienicznych. Pacjent powinien zadbać o właściwą pielęgnację okolic intymnych, by zapobiec nawrotom infekcji.
W niektórych przypadkach, np. gdy infekcja jest przyczyną niepłodności, lekarz może dodatkowo zalecić terapię wspomagającą, np. suplementację, aby poprawić jakość nasienia i zwiększyć szanse na późniejsze poczęcie.
Zapobieganie infekcjom Enterococcus faecalis w nasieniu
Najlepszym sposobem na uniknięcie problemów z bakterią enterococcus faecalis w nasieniu jest regularna profilaktyka. Kluczowe znaczenie ma dbanie o higienę intymną - codzienne mycie okolic narządów płciowych, zmiana bielizny, unikanie nadmiernego pocenia się.
- Ważne jest również regularne badanie nasienia, szczególnie u mężczyzn, którzy byli już leczeni z powodu infekcji bakterią enterococcus faecalis. Wczesne wykrycie problemu zwiększy szanse na skuteczne wyleczenie.
- Jeśli u partnera stwierdzono obecność bakterii enterococcus faecalis, oboje powinni poddać się leczeniu, by zapobiec przenoszeniu infekcji i ryzyku nawrotu.
Zachowanie higieny, samoobserwacja oraz regularne kontrole lekarskie to kluczowe elementy w walce z bakterią enterococcus faecalis w nasieniu. Tylko kompleksowe podejście zwiększy szanse na trwałe wyleczenie i uniknięcie powikłań.
Podsumowanie
Obecność bakterii enterococcus faecalis w nasieniu może powodować wiele nieprzyjemnych objawów i potencjalnie prowadzić do poważniejszych problemów zdrowotnych. Dlatego tak ważna jest wczesna diagnoza i właściwe leczenie tej infekcji pod nadzorem lekarza. Regularna higiena intymna oraz kontrolne badania stanowią kluczowe elementy zapobiegawcze.
Skuteczna walka z bakterią enterococcus faecalis w nasieniu to połączenie szybkiej diagnozy, antybiotykoterapii oraz działań profilaktycznych. Tylko kompleksowe podejście pozwoli na trwałe wyleczenie i uniknięcie nawrotów tej trudnej infekcji.





